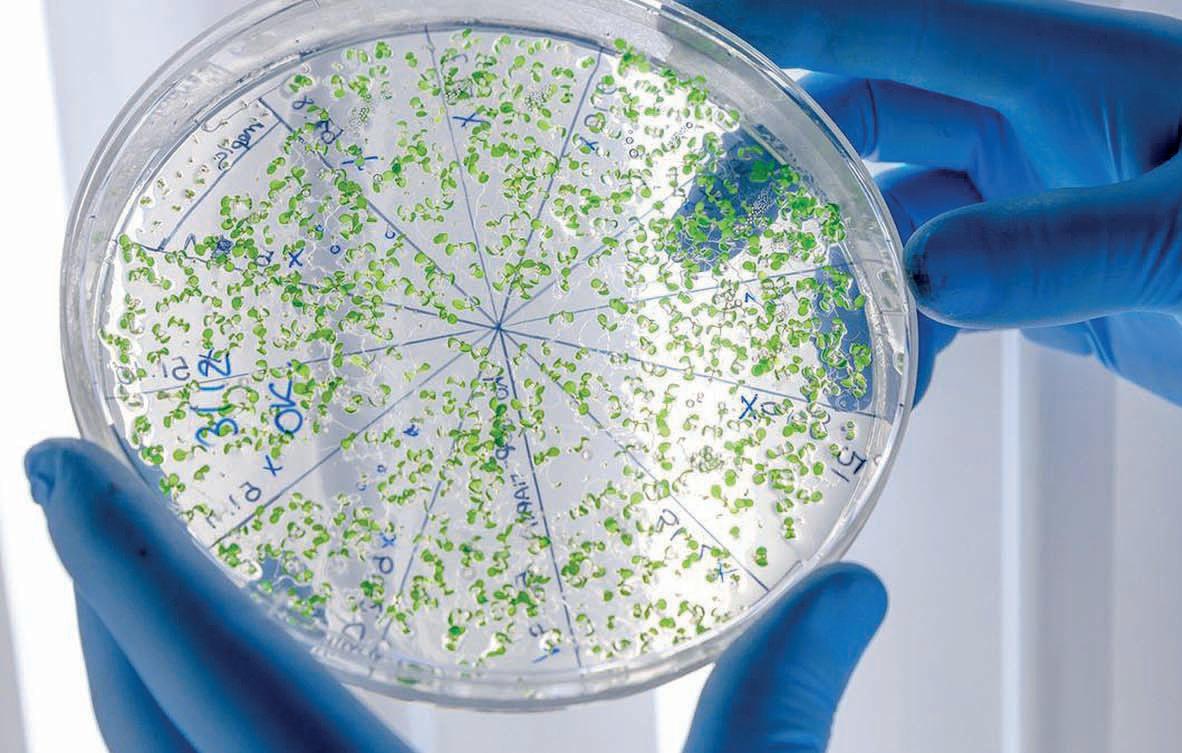

RUSOS; TEMEN EL INICIO DE UNA GUERRA
La OTAN llevará a cabo ejercicios nucleares la próxima semana. Maniobras anuales de disuasión nuclear que llegan en medio de la escalada de la guerra en Ucrania, con bombardeos rusos sobre civiles, y que han sido confirmados este martes por el secretario general de la OTAN, Jens Stoltenberg, en una comparecencia en Bruselas previa a la reunión de ministros de Defensa de la Alianza de este 12 y 13 de octubre.
En su comparecencia, Stoltenberg ha afirmado que las maniobras nucleares, bautizadas como Steadfast Noon, suponen un
El secretario general de la Alianza Atlántica, Jens Stoltenberg, afirma que los ejercicios, anuales, estaban “programados desde hace tiempo [en 2019 y 2021 también fueron en octubre]” y que no posponerlos reafirma la “predictibilidad de la OTAN, con su capacidad de disuasión y la defensa de cada uno de sus aliados”.

“entrenamiento de rutina”, previsto, y que cancelarlo sería peor, pues “la OTAN es predecible, en su capacidad de disuasión
AMLO dice que libro en su contra es “deshonestidad intelectual”

y en la defensa de todos sus aliados. El jueves presidiré una reunión ordinaria del Grupo de Planificación Nuclear. El propósito fundamental de la disuasión nuclear de la OTAN siempre ha sido preservar la paz, prevenir la coerción y disuadir la agresión. La próxima semana, la OTAN llevará a cabo su ejercicio de disuasión planificado desde hace mucho tiempo, Steadfast Noon. Es un entrenamiento que ocurre todos los años [en 2019 y 2021 también se realizaron en octubre] para mantener nuestra capacidad de disuasión de forma segura y efectiva”.

Convierte Corea del
una
El
presidente de México, Andrés Manuel López Obrador, aseguró este martes que la periodista Elena Chávez, quien revela los presuntos secretos más incómodos del mandatario en el libro “El rey del cash”, tiene “libertad para expresarse” pero que incurre en “deshonestidad intelectual”.


El líder de Corea del Norte, Kim Jong-un, inauguró el lunes una nueva granja de invernaderos construida en el lugar de una antigua base aérea donde Pionyang ponía a prueba misiles hasta el año pasado. El complejo agrario, ubicado en el condado de Hamju, al este del país, es, según el gobernante Partido de los Trabajadores, una “granja altamente automatizada” que representa un modelo para la civilización rural que busca mejorar la vida de las personas, según información de agencias.

themexicopost.mx DOW JONES 29,296.79 NASDAQ 11,039.47 BMV 45.728,87 DÓLAR Compra $ 18.90 Venta $ 20.30 EURO Compra $ 19..00 Venta $ 19.90 Circulación Certificada 65,900 ejemplaresAÑO 2MIÉRCOLES 12 OCTUBRE 2022 NO. 644 THE MEXICO POSTTHE MEXICO POST
Norte complejo de misiles en
granja de invernaderos
OTAN REALIZARÁ MANIOBRAS CON ARMAMENTO NUCLEAR TRAS BOMBARDEOS






www.themexicopost.mx @MexicoPost /MexicoPost EDITORIAL02 Miércoles 12 Octubre 2022



NACIONAL 03Miércoles 12 Octubre 2022 www.themexicopost.mx/MexicoPost @MexicoPost


NACIONAL04 Miércoles 12 Octubre 2022 www.themexicopost.mx @MexicoPost /MexicoPost



CDMX 05Miércoles 12 Octubre 2022 www.themexicopost.mx/MexicoPost @MexicoPost


www.themexicopost.mx @MexicoPost /MexicoPost CDMX06 Miércoles 12 Octubre 2022



INTERNACIONALMiércoles 12 Octubre 2022 www.themexicopost.mx/MexicoPost @MexicoPost 07



PRINCIPAL08 Miércoles 12 Octubre 2022 www.themexicopost.mx @MexicoPost /MexicoPost


PORTADA 09Miércoles 12 Octubre 2022 www.themexicopost.mx/MexicoPost @MexicoPost




www.themexicopost.mx @MexicoPost /MexicoPost INTERNACIONAL10 Miércoles 12 Octubre 2022



www.themexicopost.mx/MexicoPost @MexicoPost INTERNACIONAL 11Miércoles 12 Octubre 2022


www.themexicopost.mx @MexicoPost /MexicoPost INTERNACIONAL12 Miércoles 12 Octubre 2022


www.themexicopost.mx/MexicoPost @MexicoPost INTERNACIONAL 13Miércoles 12 Octubre 2022



www.themexicopost.mx @MexicoPost /MexicoPost DEPORTES14 Miércoles 12 Octubre 2022


www.themexicopost.mx/MexicoPost @MexicoPost ESPÉCTACULOS 15Miércoles 12 Octubre 2022
PRESIDENTE
DIRECTOR DE SOCIAL NETWORKS

SUBDIRECTORA BRENDA

JEFE
THE MEXICO POST.- REPORTEROS: GABRIEL RAMÍREZ, FRANCISCO OLASCOAGA, ROBERTO MÁRQUEZ, MARCOS ROBLES, ARMANDO VILLA, ALFREDO RENDÓN. FOTOGRAFÍA: JULIO BAUTISTA. COLUMNISTAS: “EN LA MIRA...” POR GABRIEL ZENDEJAS, “EN EL BLANCO” POR JOSÉ LUIS BELMAR, “SECURITAS ET...” POR AGUSTÍN V. SILICEO, “ESTE MÉXICO NUESTRO” POR LUIS ENRIQUE MARTÍNEZ, “ZONA CERO...” POR JAVIER DIVANY BÁRCENAS, “EL BUZÓN...” POR ALFREDO IBÁÑEZ, “SIN LÍNEA...” POR JOSÉ SÁNCHEZ LÓPEZ. GRÁFICOS: EDITH HERNÁNDEZ COYOTE. CORRESPONSALES: JUAN CARLOS VARGAS MUJICA, CECILIA GALÁN ROMERO, VICENTE GONZÁLEZ PÉREZ, ZORAYA LIZETTE FLORES MEJÍA, GABRIEL ROMERO G., VANESSA ORTÍZ. VENTAS: LUIS ENRIQUE QUINTANA VILLANUEVA, NANCY PINEDA VÁZQUEZ. CONTABILIDAD: CORPORATIVO RIVERA Y ASOCIADOS. DEPARTAMENTO JURÍDICO: FERNÁNDEZ DE CEVALLOS & PAZ JEFE DE TALLER: ROBERTO MUNGUÍA GÓMEZ. JEFE DE ROTATIVAS: FIDEL ZAMUDIO. OFICINAS GENERALES: MARIO PANI 400, LOMAS DE SANTA FE, CUAJIMALPA DE MORELOS, CIUDAD DE MÉXICO. C.P. 01219 TEL: 5585416063. DISTRIBUCIÓN: CIUDAD DE MÉXICO, ÁREA METROPOLITANA, ESTADO DE MÉXICO, JALISCO, NAYARIT, COLIMA, BAJA CALIFORNIA, SONORA, QUERÉTARO, PUEBLA, QUINTANA ROO, GUANAJUATO. PERIÓDICO IMPRESO DIARIO EDITOR RESPONSABLE: CLAUDIO JAVIER GARCÍABELTRÁN CAMACHO. NÚMERO DE CERTIFICADO DE RESERVA INSTITUTO NACIONAL DE DERECHO DE AUTOR: (04-2019-102414132700-101). NÚMERO CERTIFICADO DE LICITUD DE TÍTULO: EN TRÁMITE. NÚMERO CERTIFICADO DE LICITUD DE CONTENIDO: EN TRÁMITE. TIRAJE ESTIMADO: 68,900 EJEMPLARES GRATUITOS. PLANTAS IMPRESORAS: GLOBAL MARKETING, CALLEJÓN DEL TEJOCOTE Nº 147, EL PIRÚ, ÁLVARO OBREGÓN, CIUDAD DE MÉXICO, C.P. 01230. LAS OPINIONES VERTIDAS EN NOTAS Y COMENTARIOS SON DE EXCLUSIVA RESPONSABILIDAD DE QUIENES LAS EMITEN Y NO REPRESENTAN NECESARIAMENTE LA LÍNEA EDITORIAL. PERIÓDICO EDITADO, PUBLICITADO Y DISTRIBUIDO POR NEWSPAPER & TELEVISION S.A. DE C.V. CON DIRECCIÓN CALLEJÓN DEL TEJOCOTE Nº 147, EL PIRÚ, ALVARO OBREGÓN, CIUDAD DE MÉXICO, C.P. 01230 SÓLO SE PUBLICARÁN LOS COMENTARIOS RELACIONADOS CON LA NOTICIA Y AQUELLOS QUE CUMPLAN CON EL RESPETO A LAS PERSONAS Y LA DIVERSIDAD DE OPINIONES. SE PROHÍBE EXPRESAMENTE LA REPRODUCCIÓN O COPIA DE LOS CONTENIDOS DE ESTE MEDIO SIN EL EXPRESO CONSENTIMIENTO DE SUS EDITORES Y/O ADMINISTRADORES. NOTAS: RESPONSABILIDAD DEL REPORTERO.
JAVIER
GARCÍA
BELTRÁN C.
MEJÍA
EDUARDO
GARCÍA BELTRÁN
COORDINADOR ZONA SUR ROBERTO RODRÍGUEZ
COORDINADOR GENERAL JUAN MANUEL DIRECTORA ENLACES GUBERNAMENTALES VERÓNICA SÁNCHEZ COORDINADOR ZONA NORTE L.A.E. JUAN RUEDA RANGEL COORDINADOR DE NOTICIAS AGUSTÍN GERMÁN MÁRQUEZ
DE REDACCIÓN SANTOS SÁNCHEZ ALBARRÁN DIRECTOR GENERAL ALEJANDRO FRANCO MENDIETA DIRECTOR NACIONAL DE EDICIÓN ABRAHAM C. CASTRO CERÓN DIRECTORIO DIRECTOR DE RELACIONES PÚBLICAS ALFREDO OLMEDO DEAN DIRECTORA ADMINISTRATIVA ARACELI SÁNCHEZ GARCÉS Periódico impreso diarioAÑO 2MIÉRCOLES 12 OCTUBRE 2022 NO. 644 en redes sociales